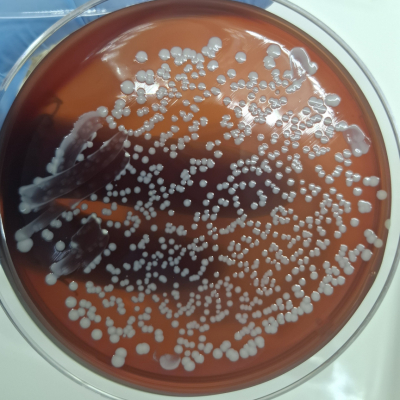
3

В отдел бактериологии, паразитологии и питательных сред Краснодарской испытательной лаборатории ФГБУ «ВНИИЗЖ» 23.01.2026 г. доставлен смыв с уха собаки для бактериологического исследования на условно-патогенную микрофлору, а также для определения чувствительности к антибактериальным препаратам. Владелец животного сообщил, что питомец расчёсывает ушные раковины, вертит головой из стороны в сторону, внутренняя поверхность ушных раковин покраснела, покрыта мелкими корочками и язвами, аппетит и активность в последнее время снижены. Самостоятельное лечение ушными каплями не приносит лечебного эффекта. По рекомендации ветеринарного врача из клиники решил обратиться в ветеринарную лабораторию. При бактериологическом исследовании материала обнаружена патогенная микрофлора: культура Staphylococcus aureus, а также условно-патогенные культуры Proteus vulgaris, Klebsiella pneumoniae, Enterococcus faecalis.
Часто владельцы собак наблюдают у своих питомцев такие симптомы отита:
Отит – это воспалительное поражение внутреннего, среднего или наружного отдела уха животного. У собак может быть вызван различными причинами: аллергическими реакциями, бактериальными, грибковыми, вирусными инфекциями, избыточной секрецией серы, в результате травмы, опухоли, наличия постороннего предмета в слуховом проходе.
Для профилактики отитов необходимо:
Для диагностики данного заболевания при наличии клинических признаков необходимо с помощью ветеринарного специалиста произвести смыв из ушной раковины питомца и отправить в ветеринарную лабораторию для проведения исследований на условно-патогенную микрофлору. Чаще всего при отитах выделяются микроорганизмы родов Staphylococcus, Streptococcus, Pseudomonas, Escherichia, Bacillus, Enterococcus и пр. После выделения возбудителя определяется чувствительность к антибиотикам и подбираются антибактериальные препараты, для местного (ушные капли) или системного лечения.
Правильно и своевременно поставленный диагноз позволит вам грамотно провести лечение с учётом чувствительности выделенной культуры возбудителя заболевания к антибактериальным препаратам, в том числе при необходимости к бактериофагам, получить лечебный эффект. Врачи отдела бактериологии, паразитологии и питательных сред Краснодарской испытательной лаборатории ФГБУ «ВНИИЗЖ» имеют обширный опыт в диагностике заболеваний у собак, вызванных условно-патогенной микрофлорой, при помощи классических бактериологических методов, а также импортных и отечественных тест-систем.
Срок исследования на условно-патогенную микрофлору обычно составляет 4-5 рабочих дней. Выданная чувствительность к антибактериальным препаратам позволит назначить животному наиболее эффективный и доступный препарат (обычно чувствительность ставится на 6 или 18 антибактериальных препаратов, клиент может указать в сопроводительном документе те препараты, на которые предпочтительнее проверить чувствительность).
Специалисты готовы незамедлительно оказать консультативную помощь в вопросах лечения и профилактики данной инфекции.
Источник: пресс-служба Краснодарского филиала ФГБУ «ВНИИЗЖ».